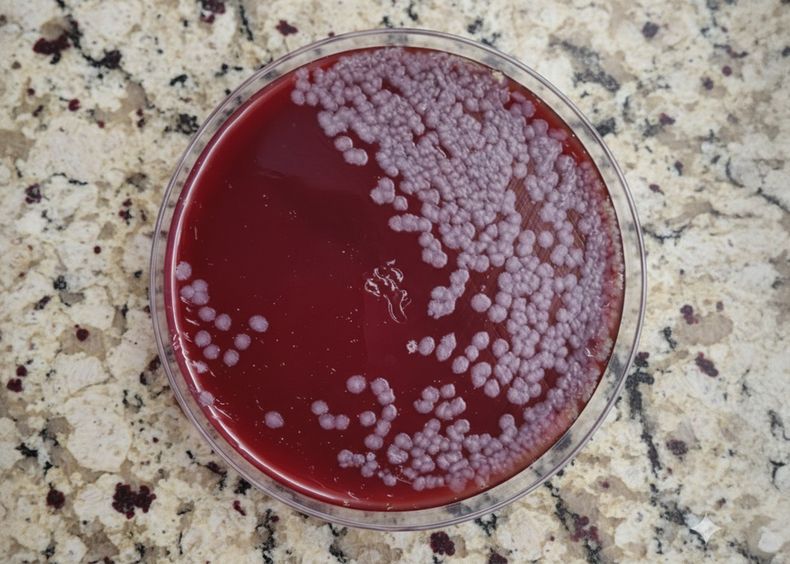
El Laboratorio Azul confirmó el diagnóstico de carbunclo en las muestras tomadas.

El Laboratorio Azul confirmó un nuevo caso positivo de carbunclo bacteriano en un establecimiento ganadero del partido bonaerense de General Alvear, ubicado en el centro provincial. La detección de la bacteria Bacillus anthracis —agente causal del también llamado ántrax— encendió las alarmas sanitarias en una región que ya se encontraba bajo emergencia agropecuaria por factores climáticos.
La alerta se activó a partir de la mortalidad súbita de animales en un campo dedicado a la producción ganadera en la zona, lo que llevó al envío de muestras al Laboratorio Azul, referencia nacional en esta enfermedad. El resultado fue categórico: se detectó Bacillus anthracis, la bacteria responsable de esta zoonosis de alta peligrosidad.
Frente a este escenario, se reiteraron recomendaciones clave:
No manipular animales muertos por causas desconocidas ni abrir sus cuerpos, para evitar la diseminación de esporas al suelo.
Vacunación obligatoria: Se recordó la vigencia de la Ley Provincial N° 6.703, que establece la vacunación anual contra carbunclo en la provincia de Buenos Aires.
Eliminación segura de cadáveres: Se debe optar por la incineración o el entierro profundo con cal, evitando siempre la apertura de los animales.
Contexto agravado por la emergencia agropecuaria
El hallazgo se da en un contexto de vulnerabilidad. General Alvear ya había sido declarada en emergencia agropecuaria debido a fenómenos climáticos adversos, lo que impacta directamente sobre la sanidad y la capacidad de respuesta de los productores.
Las lluvias intermitentes y la humedad, sumadas a la falta de infraestructura adecuada, generan condiciones propicias para la persistencia de la bacteria en el ambiente.
Signos clínicos a vigilar y respuesta técnica
Entre los signos característicos del carbunclo bacteriano se destacan:
-
Muertes súbitas sin signos previos.
-
Pérdida de sangre oscura y no coagulada por los orificios naturales (nariz, boca, ano).
Ante la confirmación de un foco activo, las autoridades sanitarias y especialistas en sanidad animal enfatizan la importancia de vacunar de forma inmediata a todo el rodeo sano, bajo supervisión técnica.
Asistencia técnica y coordinación con Senasa
Desde el Sistema Nacional de Sanidad Animal (Senasa) se insta a los productores a notificar de inmediato cualquier sospecha y a seguir los protocolos establecidos para contener la enfermedad y evitar su propagación a otros establecimientos e incluso a seres humanos.
Carbunclo bacteriano es una enfermedad que no da tregua. Frente a cada nuevo caso, se renueva la necesidad de reforzar estrategias preventivas, mejorar la vigilancia epidemiológica y fomentar la articulación público-privada en la sanidad rural.